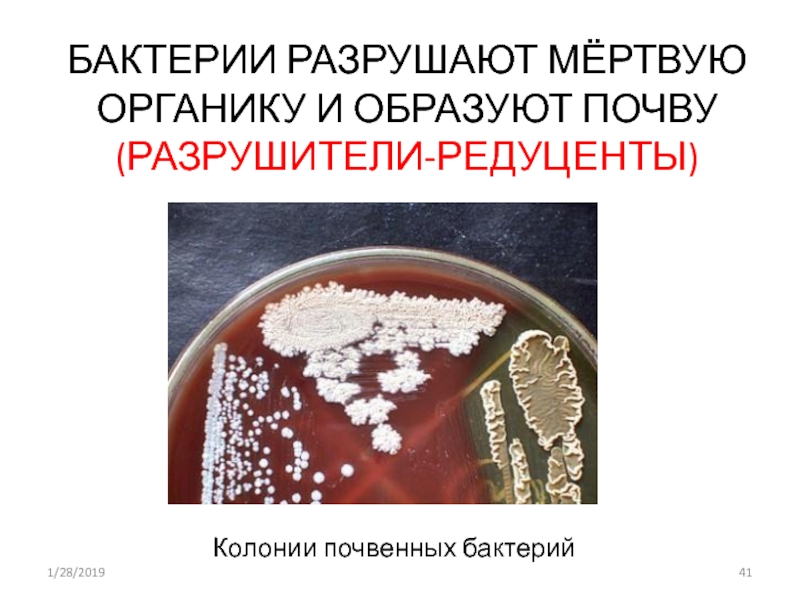

Слайд 1
Задание 3. Многообразие организмов
Многообразие организмов
Бактерии
Грибы общая характеристика грибов
многообразие грибов
Лишайники
Вирусы
Слайд 5эврифагия
(греч. eurys широкий + phagein есть, пожирать; син.: всеядность, пантофагия)
способность питаться разнообразной по составу пищей растительного и животного происхождения;
характерна для человека и некоторых видов животных.
Стенофа́гия (от греч. στενός — «узкий, ограниченный» и φᾰγεῖν — «есть, пожирать») — узкоспециализированное питание животных за счёт единственного вида пищи (монофагия) или нескольких, но немногих её видов (олигофагия), обычно близкими по своему составу.
Биологическое преимущество стенофагии — эффективное использование немногих видов пищи в связи с хорошей адаптацией к ним. Она создает изоляцию с близкими по пищевому режиму видами, но при изменении условий обитания приводит к угрозе вымирания или к резким колебаниям численности (её недостаток).
Обычно присуща биоценозам с богатым видовым составом (например, фауне тропических лесов) и реже встречается у животных, обитающих в высоких широтах, где обычно биоценозы бедны видами (там больше кормовой базы, этому способствуют спячка, нагул, запасание кормов и кочёвки животных, позволяющие удерживать относительно устойчивый рацион.
Он приспособился питаться почти исключительно побегами и листьями эвкалипта, которые волокнисты и содержат мало белка, зато содержат много фенольных итерпеновых соединений, ядовитых для большинства животных. Кроме того, молодые побеги, особенно ближе к осени, содержат синильную кислоту. Благодаря их ядовитым свойствам пищевая конкуренция со стороны других животных у коалы чрезвычайно мала — кроме него листьями эвкалипта питаются только кольцехвостый поссумPseudocheirus peregrinus и сумчатая летяга Petauroides volans.
Чтобы не отравиться, коалы выбирают в пищу только те виды эвкалиптов, которые содержат меньше фенольных соединений. Как следствие, из 800 видов эвкалипта коалы питаются всего 120 видами.

Слайд 7Миксотрофы
К миксотрофам относятся имеющие хлорофилл жгутиковые простейшие, способные в
сильно загрязненных водоемах питаться органическими веществами.
Слайд 8АВТОГЕТЕРОТРОФ
Водоросль или цианобактерия
Ф
О
Т
О
МИКО
БИОНТ
ГРИБ
ФУНКЦИИ «КОРНЯ»: защищает от высыхания; участвует в проведении
воды с минеральными веществами
ФУНКЦИИ «ЛИСТА":
снабжает
органическими веществами, созданными в процессе
фотосинтеза
симбиоз
Слайд 9Домашнее задание.
§ 11. Задачи 11.3,4 из задачника-практикума. Сообщения (по 2
минуты) о возбудителях заболеваний
(дизентерия, холера, бруцеллёз, дифтерия, столбняк, чума)
по плану:
1. путь попадания в организм;
2. где поселяются в организме;
3. что предпринять, чтобы не заболеть.
Слайд 10УЧЁНЫЕ-МИКРОБИОЛОГИ
ЛУИ ПАСТЕР
РОБЕРТ КОХ
Слайд 12Нитрифицирующие бактерии, способные окислять аммиак, образующийся при гниении органических остатков,
сначала до азотистой, а затем до азотной кислоты:
2NH3 + 3O2 = 2HNO2 +
2H2O + энергия
2НNО2 + O2 = 2HNO3 + энергия
Азотная кислота, реагируя с минеральными соединениями почвы, образует нитраты, которые хорошо усваиваются растениями.
Серобактерии окисляют сероводород и накапливают в своих клетках серу:
2Н2S + О2 = 2Н2О + 2S + энергия
При недостатке сероводорода бактерии производят дальнейшее окисление серы до серной кислоты:
2S + 3О2 + 2Н2О = 2Н2SО4 + энергия
Железобактерии окисляют двухвалентное железо до трехвалентного:
4FeCO3 + O2 + H2O = 4Fe(OH)3 + 4CO2 + энергия
Водородные бактерии используют энергию, выделяющуюся при окислении молекулярного водорода:
2Н2 + О2 = 2Н2О + энергия
Слайд 14Трудно найти место на земном шаре, где не было бы
бактерий. Их находили в струях гейзеров с температурой около 105
, сверхсоленых озерах, например в знаменитом Мертвом море, живые бактерии были обнаружены в вечной мерзлоте Арктики, где они пробыли 2-3 млн. лет, в океане, на глубине 11км, на высоте 41км в атмосфере, в недрах земной коры на глубине нескольких километров.
Бактерии прекрасно себя чувствуют в воде, охлаждающей ядерные реакторы; остаются жизнеспособными, получив дозу радиации в 10 тыс. раз превышающую смертельную для человека. Они выдерживали двухнедельное пребывание в глубоком вакууме; не погибали и в открытом космосе, помещенные туда на 18 часов, под смертоносным воздействием солнечной радиации.
Слайд 171 – носток; 2 – анабена; 3 – осциллятория; 4
– лингбия
есть одноклеточные, колониальные и многоклеточные формы. У ностока нити
склеиваются, образуя колонии размером со сливу.
Клетки в нитях (трихомах) соединены плазмодесмами, у некоторых видов в нитях встречаются крупные неокрашенные клетки – гетероцисты, в которых происходит фиксация азота. Остатки древних цианобактерий, существовавших более 3 млрд. лет назад, найдены в строматолитах – конусообразных или колоннообразных образованиях, в которых обширные колонии цианобактерий пропитывались и укреплялись солями кальция. Современные строматолиты образуются в мелководных водоемах в районах с жарким и сухим климатом.
Слайд 18
Строение бактериальной клетки:
1 — цитоплазматическая мембрана;
2 — клеточная стенка из
муреина ;
3 — слизистая капсула;
4 — цитоплазма;
5 — хромосомная ДНК;
6 — рибосомы;
7 — мезосома;
8 — фотосинтетические мембраны;
9 — включения;
10 — жгутики;
11 — пили.
Слайд 19Генетический материал представлен кольцевыми молекулами ДНК. Эти ДНК можно условно
разделить на «хромосомные» и плазмидные. «Хромосомная» ДНК (5) — одна,
прикреплена к мембране, содержит несколько тысяч генов, в отличие от хромосомных ДНК эукариот она не линейная, не связана с белками. Зона, в которой расположена эта ДНК, называется нуклеоидом.
Плазмиды — внехромосомные генетические элементы, представляют собой небольшие кольцевые ДНК, не связаны с белками, не прикреплены к мембране, содержат небольшое число генов. Количество плазмид может быть различным.
Слайд 20В бактериальной клетке отсутствуют все мембранные органоиды, характерные для эукариотической
клетки (митохондрии, пластиды, ЭПС, аппарат Гольджи, лизосомы).
В цитоплазме бактерий находятся
рибосомы 70S-типа (6) и включения (9). Как правило, рибосомы собраны в полисомы. Каждая рибосома состоит из малой (30S) и большой субъединиц (50S). Функция рибосом: сборка полипептидной цепочки.
Включения могут быть представлены глыбками крахмала, гликогена, волютина, липидными каплями.
У многих бактерий имеются жгутики (10) и пили (фимбрии) (11). Жгутики не ограничены мембраной, имеют волнистую форму и состоят из сферических субъединиц белка флагеллина. Эти субъединицы расположены по спирали и образуют полый цилиндр диаметром 10–20 нм. Жгутик прокариот по своей структуре напоминает одну из микротрубочек эукариотического жгутика. Количество и расположение жгутиков может быть различным.
Пили — прямые нитевидные структуры на поверхности бактерий. Они тоньше и короче жгутиков. Представляют собой короткие полые цилиндры из белка пилина. Пили служат для прикрепления бактерий к субстрату и друг к другу. Во время конъюгации образуются особые F-пили, по которым осуществляется передача генетического материала от одной бактериальной клетки к другой

Слайд 21Спорообразование у бактерий — способ переживания неблагоприятных условий. Споры формируются обычно
по одной внутри «материнской клетки» и называются эндоспорами. Споры обладают
высокой устойчивостью к радиации, экстремальным температурам, высушиванию и другим факторам, вызывающим гибель вегетативных клеток.
Размножение. Бактерии размножаются бесполым способом — делением «материнской клетки» надвое. Перед делением происходит репликация ДНК.
Редко у бактерий наблюдается половой процесс, при котором происходит рекомбинация генетического материала. Следует подчеркнуть, что у бактерий никогда не образуются гаметы, не происходит слияние содержимого клеток, а имеет место передача ДНК от клетки-донора к клетке-реципиенту. Различают три способа передачи ДНК: конъюгация, трансформация, трансдукция.
Слайд 22Конъюгация — однонаправленный перенос F-плазмиды от клетки-донора в клетку-реципиента, контактирующих друг
с другом. Имеет большое значение в природе, поскольку способствует обмену
полезными признаками при отсутствии истинного полового процесса. При этом бактерии соединяются друг с другом особыми F-пилями (F-фимбриями), по каналам которых фрагменты ДНК и переносятся. Конъюгацию можно разбить на следующие этапы:
1) раскручивание F-плазмиды, 2) проникновение одной из цепей F-плазмиды в клетку-реципиента через F-пилю,
3) синтез комплементарной цепи на матрице одноцепочечной ДНК (происходит как в клетке-доноре (F+), так и в клетке-реципиенте (F-)).
Трансформация — однонаправленный перенос фрагментов ДНК от клетки-донора к клетке-реципиенту, не контактирующих друг с другом. При этом клетка-донор или «выделяет» из себя небольшой фрагмент ДНК, или ДНК попадает в окружающую среду после гибели этой клетки. В любом случае ДНК активно поглощается клеткой-реципиентом и встраивается в собственную «хромосому».
Трансдукция — перенос фрагмента ДНК от клетки-донора к клетке-реципиенту с помощью бактериофагов.
Слайд 23Размножение
днк
оболочка
цитоплазма
Слайд 26Схематическое изображение конъюгации у бактерий.
1. Клетка-донор выпускает половой пиль.
2. Пиль
прикрепляется к клетке-реципиенту, соединяя две клетки.
3. В мобильной плазмиде происходит
однонитевой разрыв, и одна цепь ДНК переходит в клетку-реципиент.
4. Обе клетки достраивают вторую цепь ДНК плазмиды, восстанавливая двуцепочечную кольцевую плазмиду, и образуют половые пили. Теперь обе клетки являются полноценными донорами.
Для успешной конъюгации бактериальные клетки не обязательно должны принадлежать к одному виду. Показана даже возможность передачи посредством конъюгации генов от бактерий эукариотам: растениям и грибам. Например, бактерии рода Agrobacterium (семейство Rhizobia) содержит Ti и Ri плазмиды, которые переносятся в клетки растений, внедряются в ядро и изменяют их метаболизм, в результате чего клетки начинают вырабатывать опины, которые Agrobacterium использует как источник углерода и энергии. В Ti и Ri плазмидах существуют две системы генов, кодирующих свой перенос. Это vir гены для переноса в растения и tra гены для переноса в другие бактерии.
Слайд 30Царство Bacteria
Отдел Firmicutes
Класс Thallobacteria
Порядок Actinomycetales
Представители: Actinomyces, Streptomyces, Nocardia
Mycobacterium tuberculosus.
Актиномицеты (лучистые грибки) - это прокариоты, образующие
Мицелий (грибницу) -
тело, состоящее из тонких ветвящихся нитей –гиф диаметром 0,1 мкм
(рис.14). Мицелий актиномицетов обычно снежно-белого цвета, реже образуются пигменты, которые выделяются в окружающую среду. Мицелий актиномицетов чаще состоит из воздушной и субстратной частей. Субстратный мицелий погружен в питательную основу - субстрат и служит для питания. Воздушный мицелий находится над субстратом и служит для размножения.
Цитологические актиномицеты - типичные прокариоты. Тело одноклеточное, имеется Нуклеоид, Мезосомы, рибосомы 70S-типа. Клеточная стенка грамположительная, содержит до 90% Пептидогликана (муреина).
воздушный мицелий
Субстратный мицелий
Слайд 31Размножение чаще спорами. На кончиках воздушного мицелия имеются различного вида
спороносцы , в которых образуются споры двумя основными способами: Фрагментацией и
сегментацией.
При Фрагментации
Гифы распадаются на палочковидные и кокковидные клетки, из которых образуются споры.
Виды спороносцев: А –неспиральные; Б- спиральные; В – мутовчатые
Актиномицеты весьма засухоустойчивы. Их количество велико в сухих почвах, там, где бактерии угнетены.
Значение актиномицетов
1). Минерализаторы органического вещества в природе, компоненты круговорота веществ.
2).Участвуют в системе гумусообразования.
3).Используются для получения антибиотиков.
4).Вызывают болезни животных и человека - Актиномикозы (туберкулез, проказа).
Слайд 32Факультативные анаэробы- используют растворенный кислород, когда это возможно, при отсутствии
его живут за счет энергии анаэробных процессов.
Молочнокислые бактерии, многие бактерии,
выделяемые от больных, являются факультативными анаэробами (энтеробактерии, стрептококки, стафилококки).
Слайд 33Бактерии впитывают вещества извне, разрывают их молекулы на части, из
этих частей собирают свою оболочку и пополняют своё содержимое (так
они растут), а ненужные молекулы выбрасывают наружу. Оболочка и мембрана бактерии позволяет ей впитывать только нужные вещества.
Слайд 36Бактерии принимают участие в выветривании горных
пород и минералов.
Железобактерии
сформировали
крупные отложения железных руд.
Слайд 37КЛУБЕНЬКОВЫЕ БАКТЕРИИ - род бактерий, образующих на корнях многих бобовых
растений клубеньки и фиксирующих
молекулярный азот воздуха в условиях симбиоза с
растением.
Вступают в симбиоз с бобовыми растениями. Поселяясь в корнях
бобовых, они вызывают образование на них клубеньков, за что
и получили название клубеньковых бактерий. Растение
поставляет бактериям необходимые им для роста и развития
углеводы и минеральные соли, а взамен получает азот,
который клубеньковые бактерии способны фиксировать.
Филиппова Наталья Юрьевна учитель биологии категория высшая
Слайд 39БАКТЕРИИ, ОБИТАЮЩИЕ В СЛОЖНОМ
ЖЕЛУДКЕ ЖВАЧНЫХ, ПОМОГАЮТ РАСЩЕПЛЯТЬ
КЛЕТЧАТКУ.
Слайд 40БАКТЕРИИ ПОМОГАЮТ ПЕРЕВАРИВАТЬ ЦЕЛЛЮЛОЗУ
ТЕРМИТЫ ПИТАЮТСЯ ДРЕВЕСИНОЙ. БЕЗ БАКТЕРИЙ, ЖИВУЩИХ В
ИХ КИШЕЧНИКЕ, ПОГИБАЮТ.
Слайд 41БАКТЕРИИ РАЗРУШАЮТ МЁРТВУЮ ОРГАНИКУ И ОБРАЗУЮТ ПОЧВУ (РАЗРУШИТЕЛИ-РЕДУЦЕНТЫ)
Колонии почвенных бактерий
Слайд 44Рост микробной культуры – это процесс увеличения размеров клеток микроорганизмов
и их количества.
Слайд 45Естественной питательной средой
для роста микробной культуры являются:
Молоко и
молочные
продукты
сыворотка
Отходы производства
пищевых
продуктов
овощи
яйца
Слайд 47Кривая роста микробной культуры:
I — период задержки роста;
II — период
быстрого роста; III — период зрелости;
IV — период отмирания.
число клеток
Слайд 54ПРИЧИНЫ ВЫДЕЛЕНИЯ ГРИБОВ В ОТДЕЛЬНОЕ ЦАРСТВО
ПРИЗНАКИ РАСТЕНИЙ
Неограниченный рост
Поглощают воду и
минеральные вещества
Неподвижны
Способны синтезировать витамины
Дышат кислородом
Клетки многоядерные
ПРИЗНАКИ ЖИВОТНЫХ
Лишены хлорофилла
Питаются гетеротрофно
В оболочке
клетки хитин
Запасный продукт – гликоген
Способны образовывать мочевину
Слайд 55ОТДЕЛ НАСТОЯЩИЕ ГРИБЫ:
класс хитридиомицеты
класс аскомицеты
класс базидиомицеты
класс дейтеромицеты
класс зигомицеты
ОТДЕЛ ООМИЦЕТЫ
ОТДЕЛ ЛИШАЙНИКИ
ОТДЕЛ
СЛИЗЕВИКИ
СИСТЕМАТИКА ГРИБОВ
Слайд 58МИКОЛОГИЯ - НАУКА О ГРИБАХ
( от греческого «микос» - гриб,
«логос» - учение)
МИКОРИЗА
(грибокорень) –
сожительство
гиф гриба и
высших
растений
Эктотрофная микориза на примере
сосны. Справа грибокорень,
сформированный Pisolithus.
Слева – корень сосны,
не участвующий в симбиозе
Слайд 61Вегетативные гифы грибов:
А — без поперечных перегородок (несептированные);
Б —
с перегородками (септированные);
В — с неполными перетяжками
Слайд 63ЭКОЛОГИЧЕСКИЕ ГРУППЫ ГРИБОВ
симбионты
паразиты
хищники
сапротрофы
Слайд 66РАЗМНОЖЕНИЕ ГРИБОВ
Бесполое
(с помощью спор)
Половое
(с помощью половых клеток гамет)
Слайд 73Схема строения дрожжевой клетки:
Д – диктиосома;
Ж – жировая
капля;
Кст – клеточная стенка;
Мит – митохондрия;
П –
полифосфатная гранула;
ПМ – плазматическая мембрана; Руб – рубец на месте отпочковавшейся дочерней клетки;
ЦПл – цитоплазма;
ЭР – эндоплазматический ретикулум;
Яш – ядрышко
Слайд 74 В оптимальных условиях примерно за 1 ч происходит полное формирование
новой дочерней клетки. Однако одна дрожжевая клетка не может бесконечно
повторять процесс почкования.
На протяжении всего периода жизни материнская клетка среднем имеет 25—30 родовых шрамов, т. е. почкований. Сдерживающим фактором является изменение структуры клеточной оболочки, связанное с образованием рубцов, уменьшающих полезную поверхность материнской клетки, что ведет к снижению обмена веществ и содержания РНК, ДНК, протеина в клетках и в конечном счете к гибели.
Слайд 79А – спорынья; Б – проросший рожок; В – нормальный
колос и колос, пораженный головней.
спорынья относится к классу Аскомицеты. Легко обнаруживается
осенью: на колосьях среди зерновок хорошо заметны черно-фиолетовые рожки – склероции, выступающие из колоса.
Слайд 85По форме слоевища лишайники делятся
Слоевище имеет вид корочки, плотно
сросшейся с субстратом сердцевинными гифами.
Слоевище имеет вид пластинки, прикрепленной
к субстрату выростами гиф - ризинами
Слоевище имеет вид разветвленного кустика либо неразветвленных стоячих столбиков. К субстрату они прикрепляются короткой ножкой
накипные
листоватые
кустистые
Лецидея
Пармелия
Цетрария
цвет придает особое лишайниковое вещество - париетин, которое в виде оранжевых кристаллов покрывает гифы корового слоя. Чем ярче освещение в месте произрастания лишайника, тем ярче он окрашен.
Слайд 86Фенольные гликозиды клеток мхов И лишайников предотвращают их гниение, а
после отмирания способствуют образованию торфа.
Лишайниковые кислоты оказывают также тормозящее действие на
прорастание семян, развитие проростков и корневой системы травянистых и древесных растений.
Фенольные лишайниковые кислоты угнетают размножение многих бактерий и плесеней, поэтому многие лишайники практически стерильны и применялись в северных госпиталях в период Великой Отечественной войны как прокладочный материал при перевязке ран.
Слайд 90Ви́рус (от лат. virus — яд) — микроскопическая частица, способная
инфицировать клетки живых организмов. Вирусы являются облигатными паразитами — они
не способны размножаться вне клетки. В настоящее время известны вирусы, размножающиеся в клетках растений, животных, грибов и бактерий (последних обычно называют бактериофагами).
Слайд 91В 1852 году русский ботаник Дмитрий Иосифович Ивановский получил инфекционный
экстракт из растений табака, пораженных мозаичной болезнью.
В 1898 году голландец
Бейеринк ввел термин «вирус» (отлатинского – «яд»), чтобы обозначить инфекционную природу определенных профильтрованных растительных жидкостей
История изучения вирусов
Палочковидная частица
вируса табачной мозаики.
(1) РНК-геном вируса, (2) капсомер, состоящий всего из одного протомера,
(3) зрелый участок капсида.
Слайд 93Мельчайшие живые организмы
Не имеют клеточного строения
Способны жить и воспроизводиться, только
паразитируя внутри других клеток.
Большинство вызывает болезни
Устроены очень просто
Находятся на границе
живого и неживого
Каждый тип вируса распознает и инфицирует лишь определенные типы клеток
Свойства вирусов
Слайд 94Схематичное строение вируса:
1 - сердцевина (ДНК-двухцепочечная, одноцепочечная ИЛИ РНК-двухцепочечная,
одноцепочечная или 2одноцепочечных РНК); 2 - белковая оболочка (капсид); 3
- дополнительная липопротеидная оболочка; 4 - капсомеры (структурные части капсида).
Строение вируса
Слайд 97Вирус полиомиелита
Вирус гриппа
Вирус герпеса
Вирус ВИЧ
Аденовирус
Филиппова Наталья Юрьевна учитель биологии категория
высшая
Слайд 100Грипп
Оспа
(1977 посл вспышка)
Краснуха
Свинка
Бешенство
Корь
Гепатит
Желтая лихорадка
Некоторые злокачественные опухоли (раковые)
Заболевания
человека,
вызываемые вирусами:
Слайд 101Доказана также роль вирусов в заболевании раком. Нобелевский лауреат Уэнделл Стэнли в
1935г выделил такой вирус .
В 1911 году П. Раус открыл
вирус, вызывающий саркому у кур и передающийся другим птицам.
В 1936 году Биттнер обнаружил вирус, который вызывает опухоль молочной железы у мышей, и доказал, что он передается с молоком мыши. Позже ученый установил связь вирусного агента с генетическими изменениями, которые ведут к развитию рака.
Исследователь Дубелько первым вырастил культуру раковых клеток, в частности, культуру вируса полиомы мышей. Сара Стюарт в 1957 году открыла новый вирус рака и вырастила его культуру, которая вызывала рак, когда ее вводили здоровым животным.
В 50-х годах Л. Гросс сделал необычное наблюдение. У мышей в возрасте до 16 дней, которым он вводил вирус рака, развивалась лейкемия. У мышей той же породы в более старшем возрасте, которым вводился этот же вирус, развивался рак слюнных желез.
В настоящее время известно более 50 вирусов (разновидности как РНК, так и ДНК), которые вызывают рак у животных.
Слайд 102 В 1970 году было обнаружено, что некоторые вирусы выделяют необычные
ферменты, способные превращать РНК в ДНК. Этот фермент получил название
обратной транскриптазы. Вирусы, которые выделяют подобный фермент, были сгруппированы в семейство, получившее название ретровирусов.
Ретровирусы вызывают многие болезни у животных, в том числе и рак. Считается, что они вызывают некоторые заболевания и у людей, но пока остается недоказанным, что содержащие РНК вирусы рака могут внедряться в клетки человеческого организма, приводя к возникновению заболевания.
Кроме того, в развитии рака большую роль играет так называемая предрасположенность. Предрасположенность означает, что человек способен воспринять болезнь. Это во многом определяется его иммунной системой. Если у человека сильный иммунитет, то химические канцерогены, вирусы и даже умеренная радиация могут и не привести к раковым изменениям.